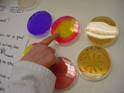

Het verschil tussen een bacterie en een virus
In de krant worden deze begrippen door elkaar gehaald.
Maar er zijn grote verschillen:

Hier boven de bacteriecel met organellen, lees meer

en hier(boven) een virus: DNA met eiwitmantel
De kenmerken van een virus
de meeste virussen zijn veel kleiner dan bacteriën maar
het werkelijke verschil (met een bacterie) betreft hun bouw en wijze van vermeerdering:
- ze bevatten slechts één type nucleïnezuur, hetzij DNA hetzij RNA omgeven door een
- eiwitmantel , capside genoemd(soms omgeven door een enveloppe van lipiden, eiwitten en koolhydraten)
- ze vermeerderen zich binnen een levende cel door de synthesestructuren van deze cel te gebruiken (hebben ze zelf niet!)en
- veroorzaken in deze cel de synthese van structuren welke het virusnucleïnezuur in staat stellen om zich van de ene naar de andere cel te begeven.
Virussen hebben geen cel, geen ribosomen,weinig of geen enzymen voor hun eigen stofwisseling, zo missen ze de enzymen voor de eiwitsynthese en ATP-productie.
Om zich te vermeerderen nemen ze in de cel van een ander organisme de controle over van de stofwisselingsfabriek van die gastheercel.
Dit maakt het erg lastig om medicijnen te vinden of te ontwikkelen tegen virusinfecties, de virussen maken gebruik van onze eigen stofwisseling, zodat stoffen die de groei van virussen in het lichaam remmen ook ingrijpen op onze eigen stofwisseling.
Medicijnen die wel werken tegen een bacterie werken niet tegen een virus.
Zie antivirale middelen,
DUS:
Antibiotica werken niet tegen virussen !!!!!
Ons lichaam kan virussen wel onschadelijk maken met antistoffen. Vaccinatie (van te voren) helpt hierdoor wel. Vaccinatie is het inenten met antigenen van het virus (en niet het virus zelf, in zijn geheel) en kan zo ons lichaam antistoffen laten vormen en zodat er cellen met een geheugen voor deze antigenen klaar staan zodat bij echte infectie zodra het betreffende virus binnendringt. Zie ook antigenen.
De bouw van een virus
De vermeerdering van een virus
Wat is het verschil tussen een bacterie en een virus?
Leeft een virus wel of niet?
Lysogenie
Transductie
Virussen op het lab
Antivirale middelen
DNA en RNA virussen